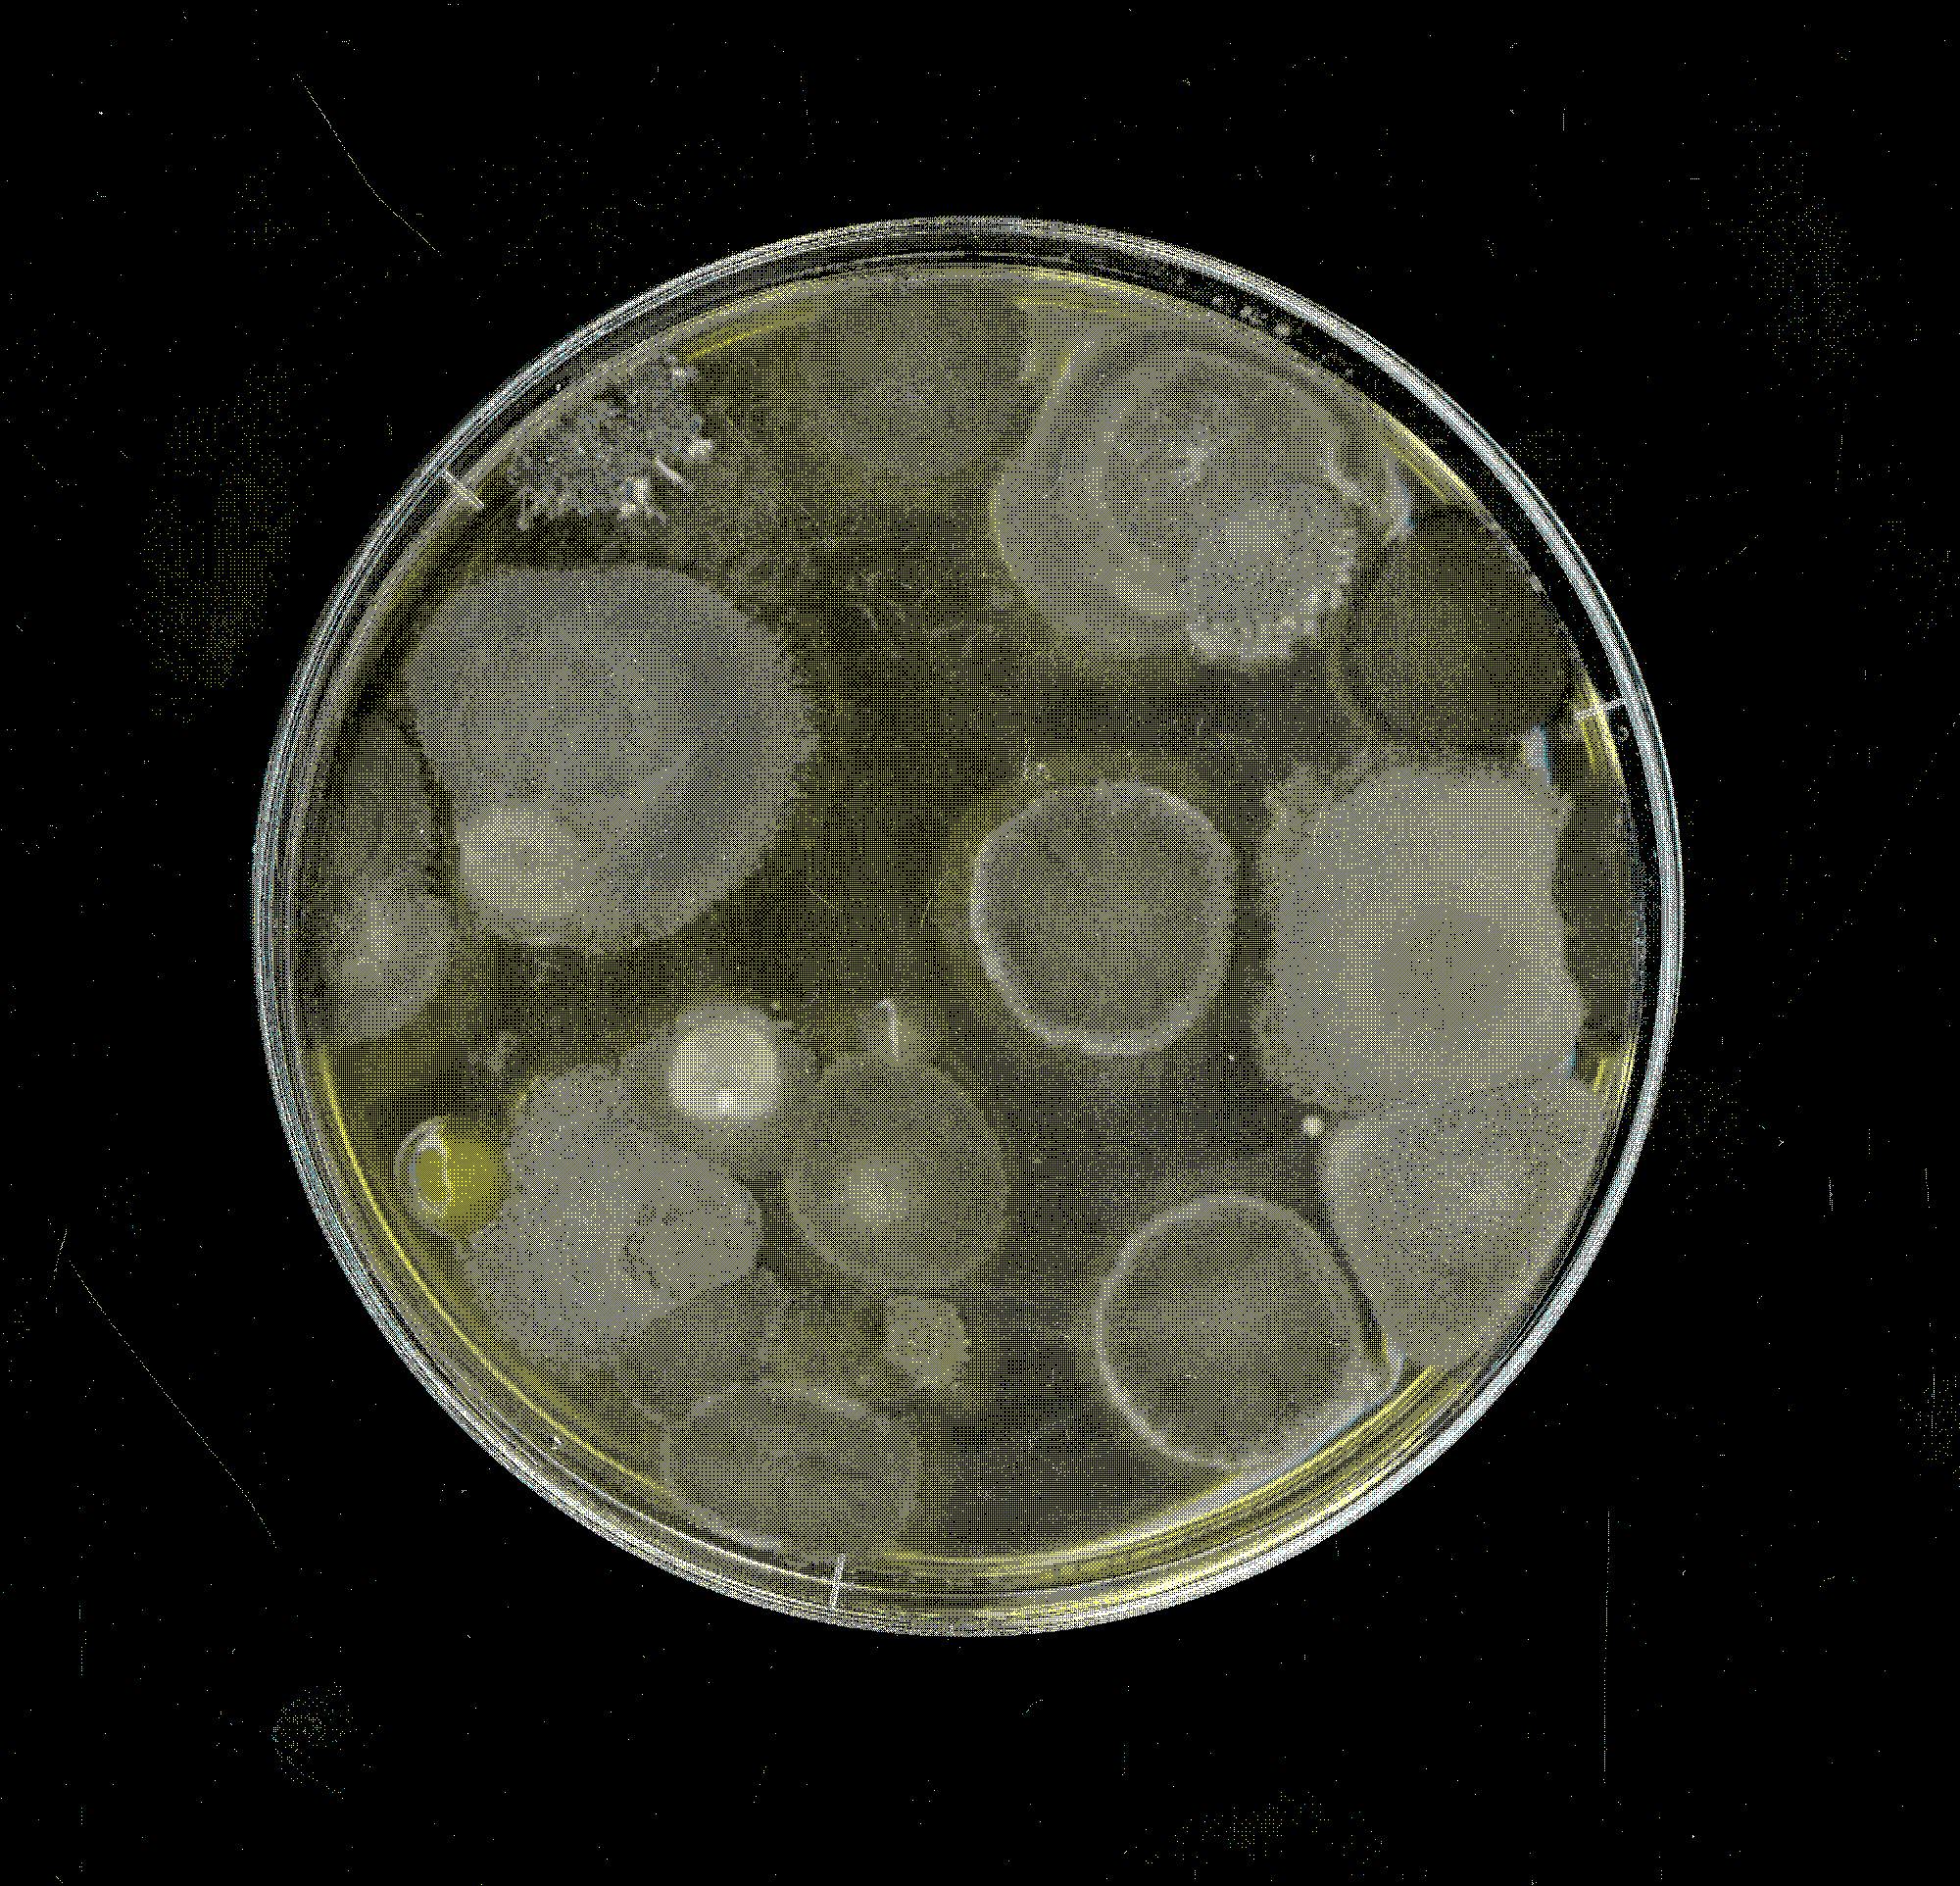
anders_dan_menselijk_1
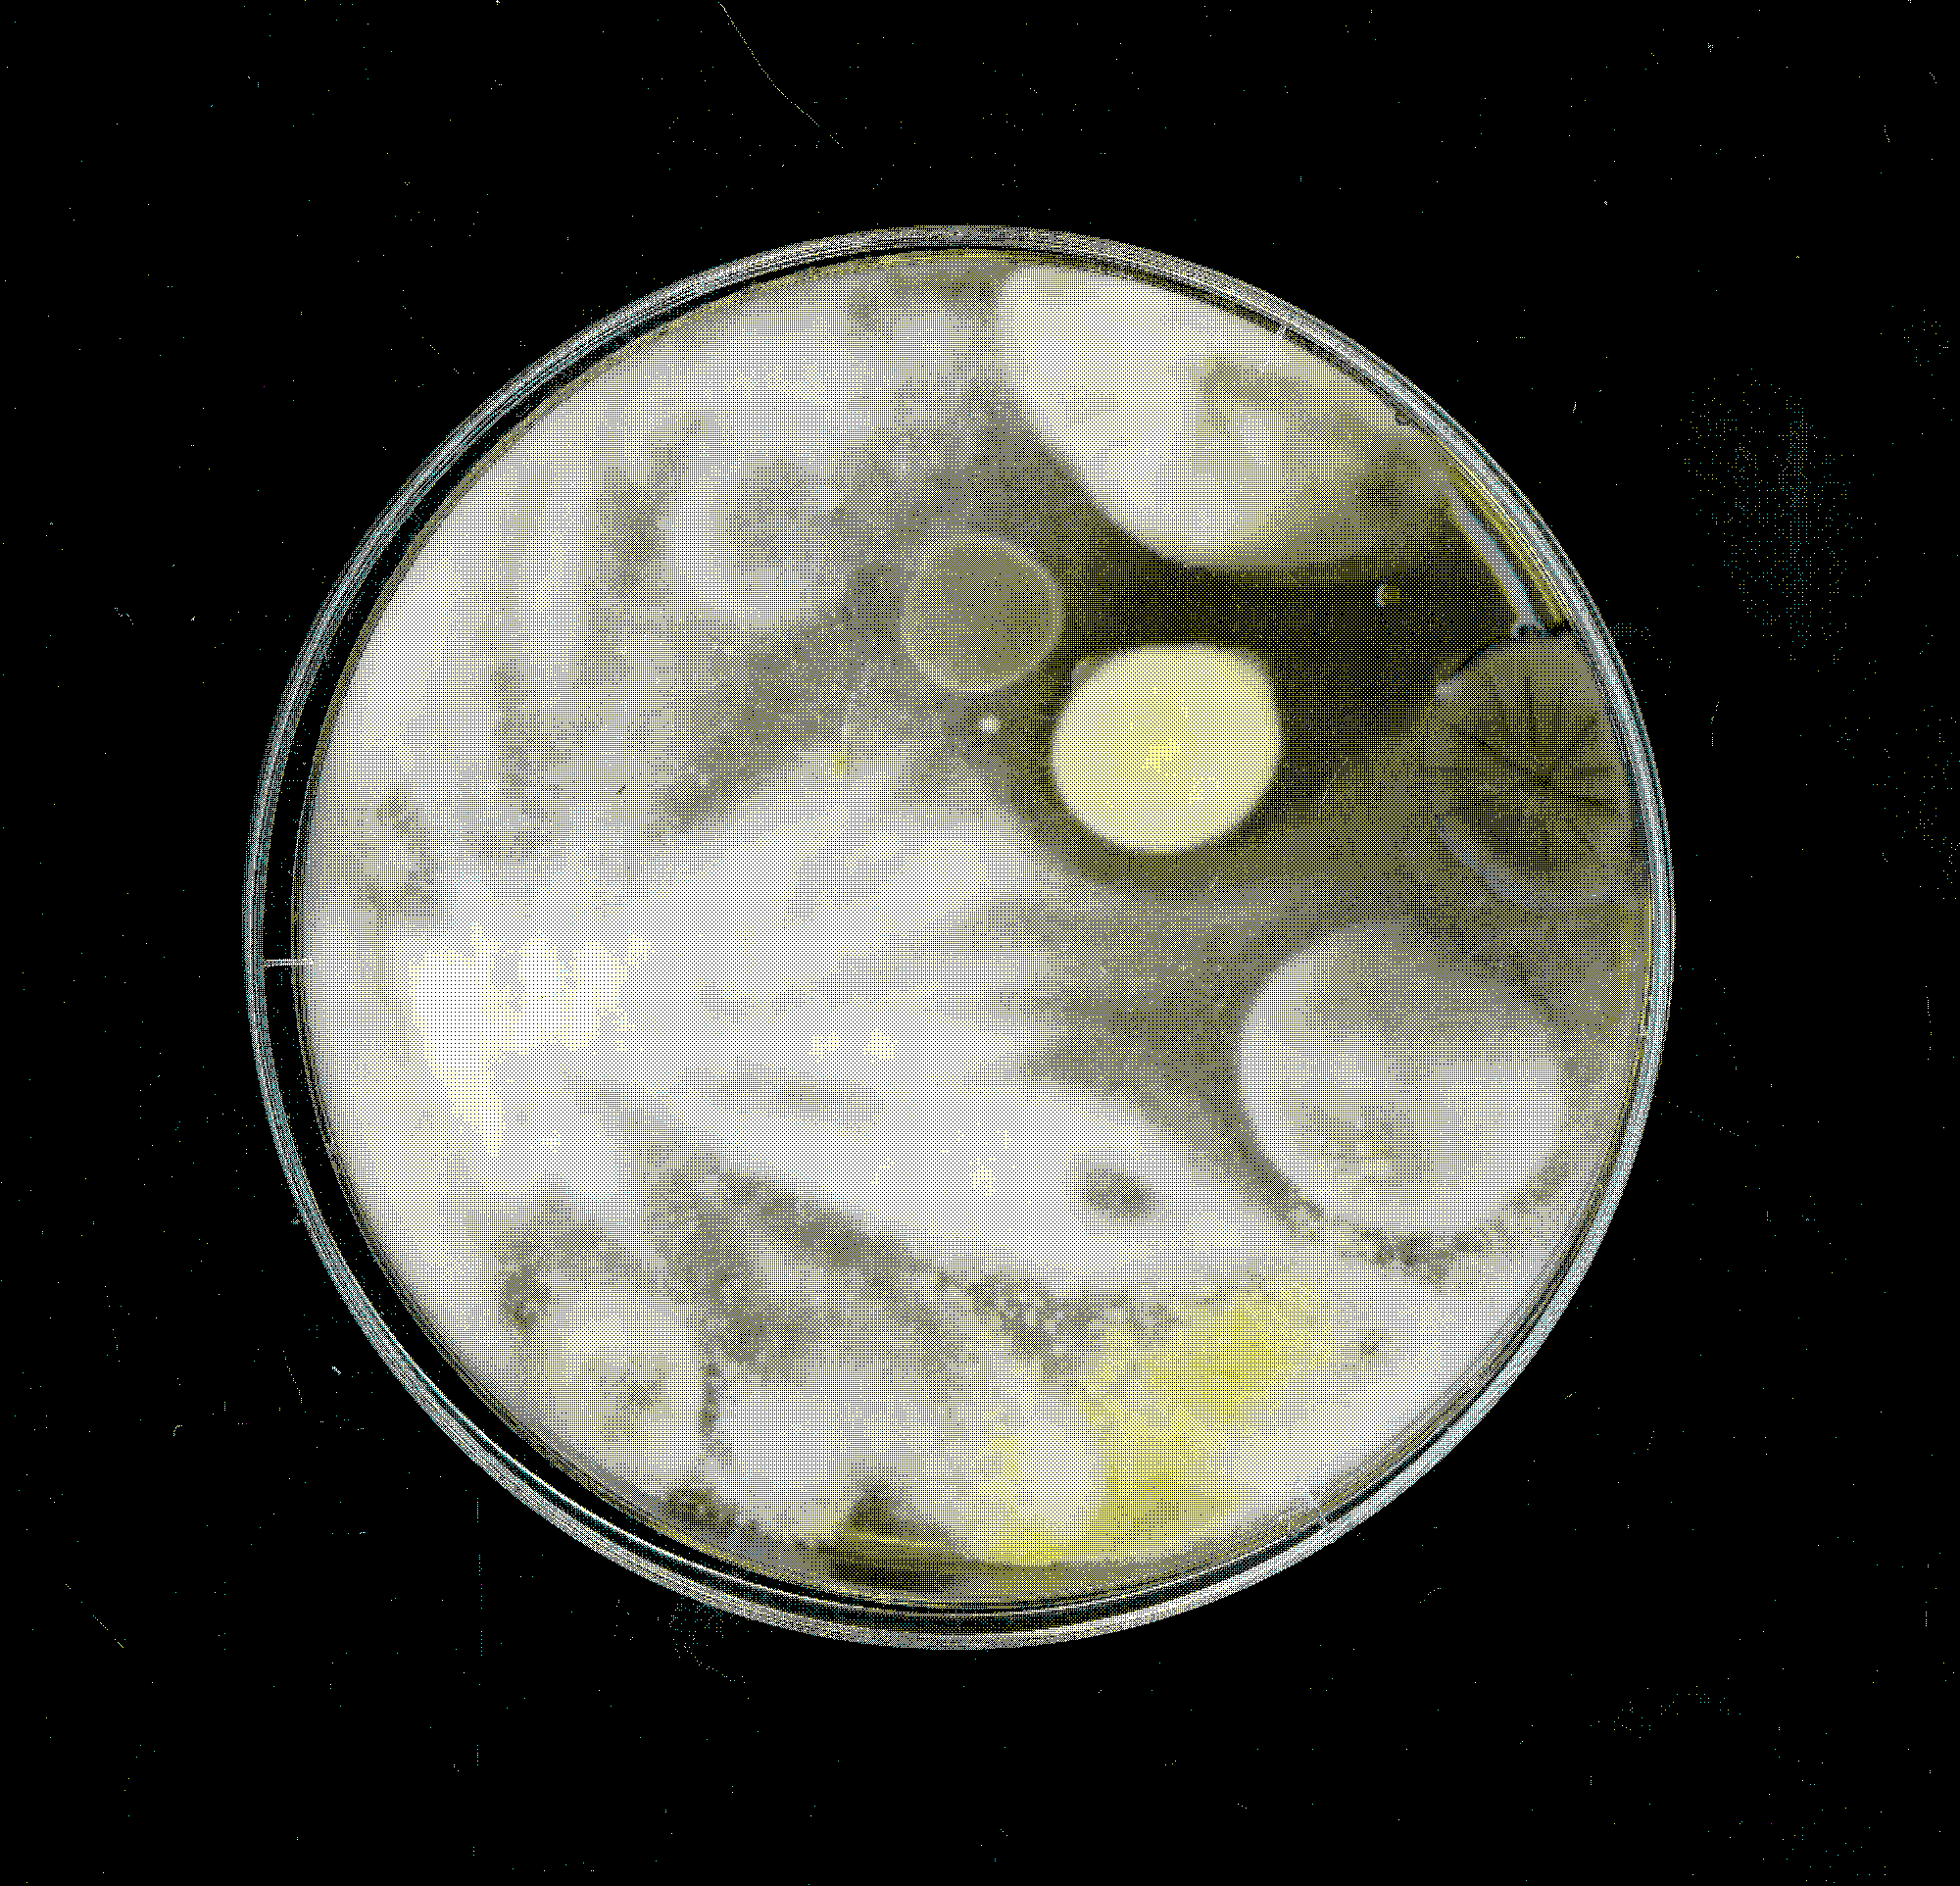
anders_dan_menselijk_2

Nieuwe petri schalen
(1/5)

Eén schaal een uur binnen
(2/5)

Links een uur binnen, recht buiten
(3/5)

The existence and recognition of non-human entities are crucial within the Symbiocene. The use of petri
dishes provides a simple way to visually represent the presence of these entities. By placing petri
dishes in a spatial context over a certain period, non-human entities can emerge over time.
This experiment consists of two variants: one dish was kept indoors, and the other was placed outdoors,
both for one hour. The aim was to investigate whether there would be a visual difference between the two
variants. As seen in the photos, this indeed turned out to be the case. The dish that was kept indoors
exhibits multiple forms that are identical to each other. In contrast, the dish that was placed outdoors
shows more variation.
This experiment demonstrates that in design, acknowledging non-human entities can lead to new visual
expressions, making the existence of all entities intriguing. It emphasises the importance of involving
non-human actors and exploring their potential within the design process. By embracing the presence of
these entities, we can discover new perspectives and possibilities that enrich our visual expressions.
Nieuwe petri schalen
(1/5)

Eén schaal een uur binnen
(2/5)

Links een uur binnen, recht buiten
(3/5)

Petrischaal binnen na 12 dagen
(4/5)
Petrischaal buiten na 12 dagen
(5/5)